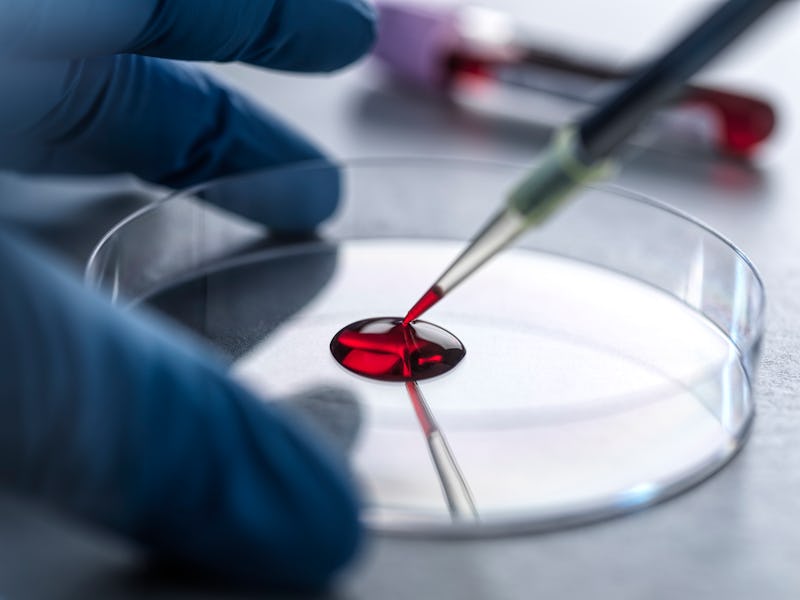

A Simple Blood Test Outperformed Doctors in Spotting This Devastating Memory Disease
Testing for Alzheimer’s could be as routine as testing cholesterol levels.
A new study from Sweden published on Sunday in the Journal of the American Medical Association (JAMA) demonstrates that a blood test can identify Alzheimer disease with greater accuracy than dementia specialists and primary care doctors using standard methods. The results were presented at the Alzheimer’s Association International Conference on Sunday in Philadelphia.
The study looked at 1,213 patients with mild memory problems. About 23 percent had subjective cognitive decline — Alzheimer’s earliest stage — 44 percent had mild cognitive impairment, and 33 percent had dementia. Primary care physicians treated about 500 of them while specialists at memory clinics treated the rest. Then, about 300 patients from each group received the blood test.
The results showed that the blood tests diagnosed Alzheimer’s 90 percent of the time. On the other hand, dementia specialists identified the disease 73 percent of the time, and primary care doctors did so only 61 percent of the time. Standard methods to diagnose this debilitating condition that affects nearly 7 million Americans involve expensive, invasive exams like PET scans and spinal taps.
The blood test homes in on a type of protein called tau, which accumulates in the brains of those diagnosed with Alzheimer’s. Specifically, it measures the amount of tau present in a person’s blood; above a certain amount is associated with Alzheimer’s disease.
The results of the blood test were confirmed again by spinal taps or PET scans. Notably, the blood test had the highest accuracy in patients whose condition had already progressed to dementia. However, the test was least accurate at diagnosing Alzheimer’s disease in its earliest stages, when people often have what’s known as subjective cognitive decline. Accuracy at this stage is important, however, as many people with subjective cognitive decline ultimately do not have Alzheimer’s, senior author Oskar Hansson, a professor of clinical memory research at Lund University in Sweden, told the New York Times.
While this blood test’s effectiveness is good news, it doesn’t surprise researchers. “It is clear, but not surprising, that the blood test offers better diagnostic accuracy than clinical evaluation, which has access to only indirect information about brain health, for example cognitive tests,” Cliff Abraham, a professor of neuroscience and psychology at the University of Otago in New Zealand who was not involved in the study, told The Washington Post.
This study demonstrates that one day diagnosing Alzheimer’s disease could be as routine as testing for cholesterol levels at annual physicals. In the paper, the researchers call for future studies to assess how blood tests for tau affects clinical care.